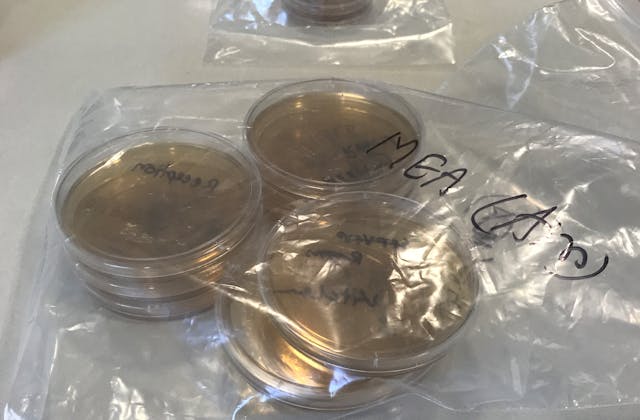

Project Info
The Golden Ratio was engaged first as a consultant and then as Principal Contractor to rectify ongoing water ingress issues with a mixed use building in Mosman. It happens to be the oldest standing shop in Mosman (c1890) but had seen little maintenance and some questionable building methods throughout it's life. We had a huge task of bringing this sick building back to a safe dwelling for the inhabitants. Works included; Extensive earthworks and underpinning, Waterproofing, Drainage, Concreting, New windows, Bricklaying (Install cavity flashings), Rendering, Aluminium window and Roof replacement, Ventilation and damp repair methods. We also renovated one of the residential units above including reconfiguration of the main bathroom to add a fourth bedroom.
Our services